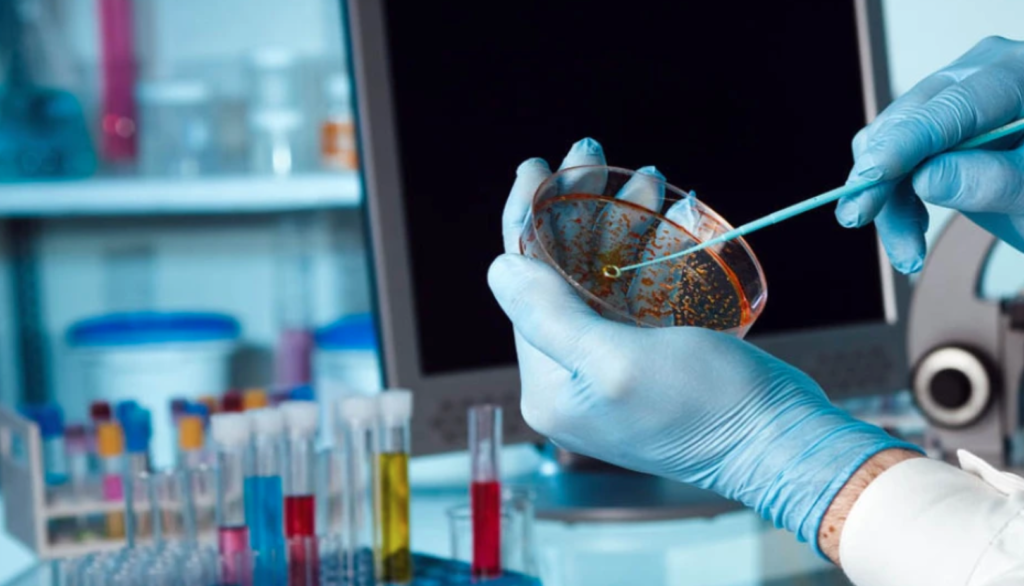

ΥΓΕΙΑ - 17/09/2021 - 8:00 μμ
Κοροναϊός-Νοσοκομείο Χαλκίδας: Κατέληξαν άλλες δύο γυναίκες μέσα σε λίγες ώρες-Ήταν ανεμβολίαστες
Οι δύο ηλικιωμένες γυναίκες έπασχαν από υποκείμενα νοσήματα
Δύο ακόμα άτομα άφησαν την τελευταία τους πνοή
στο Νοσοκομείο Χαλκίδας από επιπλοκές του κοροναϊού. Πρόκειται για δύο ηλικιωμένες γυναίκες.
Ειδικότερα, ο κορονοϊός «νίκησε» μία 83χρονη και μία 70χρονη στο Νοσοκομείο Χαλκίδας στην κλινική Covid.
Σύμφωνα με το evima.gr, και οι δύο ηλικιωμένες γυναίκες ήταν ανεμβολίαστες και έπασχαν από υποκείμενα νοσήματα.
Υπενθυνίζεται πως στην περιφερειακή ενότητα Εύβοιας ανακοινώθηκαν χθες (15.09.2021), 14 νέες μολύνσεις, σημειώνοντας έτσι νέα πτώση στα ημερήσια κρούσματα covid 19.
Πηγή άρθρου και φωτογραφίας :
ArrayΣΧΕΤΙΚΑ ΑΡΘΡΑ
Ημερίδας ενημέρωσης και ευαισθητοποίησης για τον καρκίνο του πνεύμονα
29.04.2026 - 6:30 μμ


























